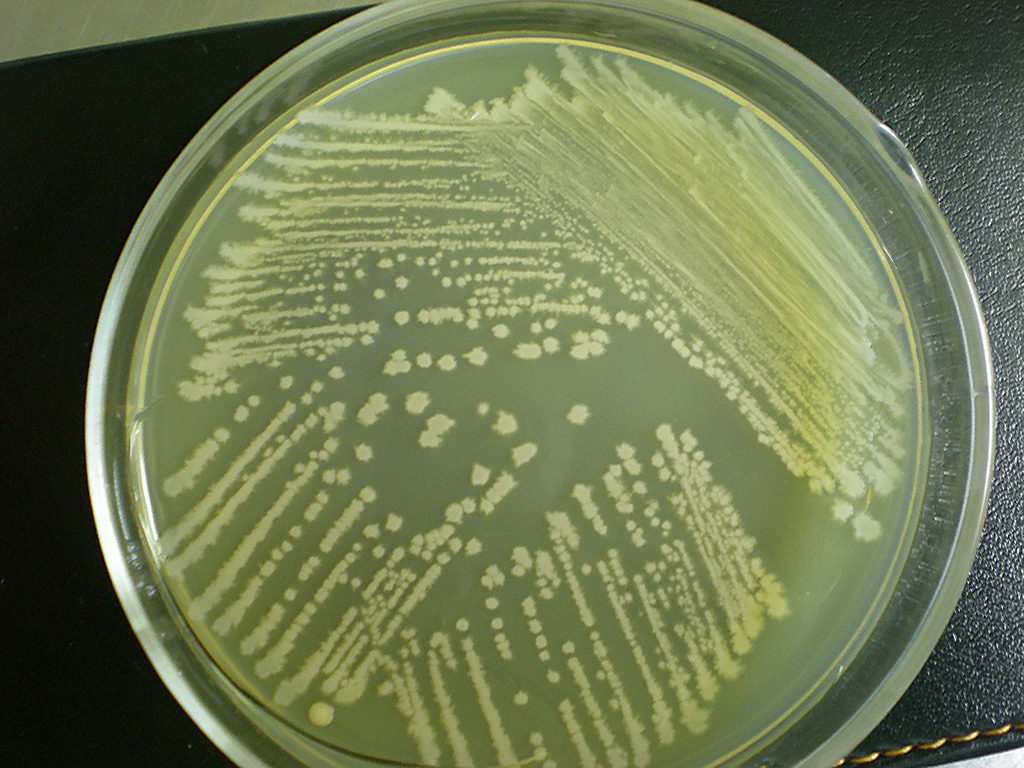

1688工业品为您提供在线免费查询更多生物化工详细参数、实时报价、规格一览表。更多关于生物化工多少钱一千克/生物化工报价明细/生物化工规格型号价格表/生物化工批发市场价格/生物化工官方报价等咨询,尽在1688工业品。询底价>
为你找到其他生物化工相关产品

浙江单油酸甘油酯生产厂家 25496-72-4 单油酸甘油酯1kg起订包邮
浙江温州
在线询价

法国 极美丝GG 甘油葡糖苷 护肤 化妆品原料 100g

广东广州
在线询价

西梅粉 川久生物 西梅果汁粉 多规格 喷雾干燥/冻干粉 西梅冻干粉
陕西西安
在线询价

批发供应 国产 橄榄油 PU级 橄榄油 唇膏口红手工皂基础油原料
广东广州
在线询价

玫瑰粉 食品级玫瑰花粉重瓣玫瑰花粉 全水溶固体饮料原料包邮
陕西西安
在线询价

歧化松香钾皂 源头工厂工业级分析纯顾客是上帝回复及时浙江福建
山东淄博
在线询价

批发供应 超细紫草粉现磨超细天然100%紫草粉
广东广州
在线询价

包邮冻干粉菌种 地衣形芽孢杆菌 编号SHBCC D11088
上海
在线询价
月桂基硫酸盐胰蛋白胨MUG肉汤(LST-MUG)
上海
在线询价

三胜肽 三元胜肽 棕榈酰三肽-1 护肤 化妆品原料 100g

广东广州
在线询价

供应 海藻胶原质 海藻提取液化妆品原料 保湿 滋润 1KG起订

广东广州
在线询价

挪威 Dermaclarine 三文鱼抗*衰焕妍精华 护肤 化妆品原料 100g

广东广州
在线询价
查看更多产品及报价
100+其他生物化工相关产品等你解锁
在线寻源3000行家正在找货
免费询价,源头正品,上1688工业品,全国的工业正品交易平台





